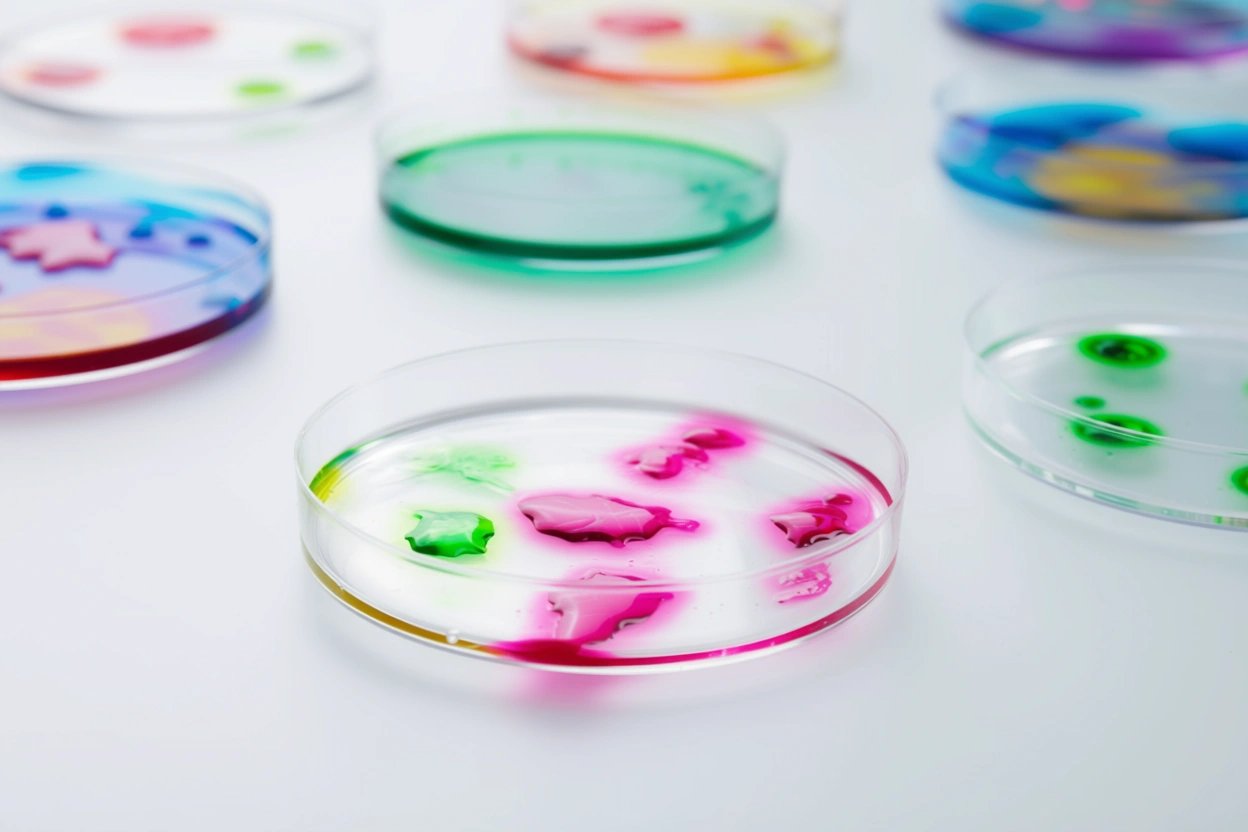
White foam cups with green background

How Plastics Are Made

Raw Materials
Include fossil-based or bio-based feedstocks and pryolysis oil (feedstock from the advanced recycling proces)

Polymerization
Create polymer chains

Compounding
Add fillers, colorants, stabilizers

Manufacturing
Shape via injection molding, extrusion, thermoforming

Consumer Benefits
Promote the safe and affordable distribution of goods across a global economy

Product Use & End-of-Life
Used, reused, recycled, or responsibly disposed
Not All Plastics Are the Same
There are seven common types of plastic, categorized by Resin Identification Codes (RICs), which were developed to streamline the recycling process by identifying the polymer type of each plastic product. These codes help consumers, recyclers, and manufacturers sort plastics more efficiently, reduce contamination in recycling streams, and promote more sustainable waste management practices.
#1 PET (Polyethylene terephthalate)
Common Products
Beverage bottles, food containers (such as peanut butter jars and ketchup bottles) take-out containers, packaging films, medical packaging, disposable lab equipment
Characteristics
Lightweight, highly transparent, shatter-resistant, energy-efficient, versatile

#2 HDPE (High-density polyethylene)
Common Products
Milk jugs, laundry detergent and shampoo bottles, toys, cutting boards, automotive parts like bumpers and inner panels, medical tubing, playground equipment
Characteristics
Chemical-resistant, UV- and weather resistant, strong, durable

#3 PVC (Polyvinyl chloride)
Common Products
Pipes, window frames, flooring, cable insulation, IV bags, medical gloves, automotive dashboards, door panels
Characteristics
Corrosion- and chemical-resistant, flame-retardant, flexible or rigid, strong and long-lasting, low maintenance

#4 LDPE (Low-density polyethylene)
Common Products
Grocery bags, squeeze bottles, six-pack rings, trash can liners, wire and cable insulation, agricultural film
Characteristics
Tough and impact-resistant, transparent and sealable, chemical-resistant, flexible and lightweight

#5 PP (Polypropylene)
Common Products
Food containers, microwaveable containers, diapers, medical masks, carpets, automotive bumpers, battery cases
Characteristics
Heat-resistant, chemical- and fatigue resistant, strong and lightweight, durable and long-lasting

#6 PS (Polystyrene)
Common Products
Insulation, food packaging, disposable cutlery, petri dishes, CD cases, home lighting fixtures
Characteristics
Rigid and strong, excellent clarity, thermal insulation properties, lightweight
#7 Other
A diverse group of specialized plastics falls under the “Other” category, representing materials engineered for performance, durability, and innovation. These resins are used across industries—from textiles and electronics to automotive, aerospace, and medical applications—where unique physical or chemical properties are required.
Common Products
Textiles and carpets (Nylon), eyewear lenses and safety shields (PC), display screens and signage (PMMA), automotive interiors and LEGO® bricks (ABS), biodegradable packaging and films (PHA, PLA)
Characteristics
Nylon (Polyamide) – Strong, flexible, and abrasion-resistant; used in fabrics, mechanical parts, and industrial components
PC (Polycarbonate) – Exceptionally tough and transparent; impact-resistant and often used as a lightweight glass alternative
PMMA (Polymethyl Methacrylate, or Acrylic) – Crystal-clear, UV-resistant, and weather-durable; used in signage, aquariums, and lenses
ABS (Acrylonitrile Butadiene Styrene) – Rigid, impact-resistant, and easily molded; ideal for durable consumer goods and electronics housings
PHA (Polyhydroxyalkanoate) – Biobased and biodegradable; produced by microorganisms and used in compostable packaging and films
PLA (Polylactic Acid) – Biobased and compostable; made from renewable resources like corn starch or sugarcane, commonly used for 3D printing and food packaging

Microplastics
While research on microplastics has expanded in recent years, substantial gaps remain in understanding their characteristics, sources, environmental fate, and potential health effects. These include how to detect and quantify them, trace their movement through environmental media, and assess actual exposure levels and potential risks. The global plastics and chemical industries are contributing to the scientific knowledge base by supporting credible research and advocating for policies grounded in evidence and feasibility.1https://plasticscircularity.org/microplastics/ The Plastics Industry Association (PLASTICS) aligns with the WHO’s position that further research is needed 2 https://www.who.int/publications/i/item/9789240054608 and is leading initiatives to reduce plastic waste and prevent its entry into the environment.
Bioplastics
A bioplastic is a plastic that is either biobased and/or biodegradable. Biobased plastic is a type of plastic material made from renewable biological sources—such as corn starch, vegetable fats, or sugarcane—instead of traditional fossil fuels. Some bioplastics, whether biobased or fossil based, are also biodegradable, designed to decompose completely via natural processes.3https://www.plasticsindustry.org/bio-page/
Biodegradable plastics are designed to break down through the action of living organisms, typically microbes such as bacteria or fungi. Under the right environmental conditions, they degrade into natural substances like water, carbon dioxide, and biomass, leaving minimal or no toxic residue.
What It Means
Can be broken down naturally by microbes (bacteria, fungi, etc.) into water, carbon dioxide, and biomass over time.
Focus
What happens at the end of its life.
Important Notes
A biodegradable product is not necessarily biobased—some petroleum-based plastics are engineered to biodegrade. Biodegradability does not mean that these products should be littered. All manufactured products should be properly disposed of through contained waste management channels. Compostability is a type of biodegradability in which products break down under specified conditions of time, temperature, and moisture.
Bioplastics are derived from biobased sources, meaning their carbon originates from renewable plant materials rather than fossil fuels. The core principle is simple: follow the carbon as it moves from the atmosphere into plants and eventually into plastic products.
What It Means
Made (partially or fully) from renewable biological sources like plants, corn, sugarcane, or algae instead of fossil fuels.
Focus
Where the material comes from.
Important Notes
A biobased product is not necessarily biodegradable. The carbon absorbed by the plants from the atmosphere helps to offset emissions throughout the manufacturing process. Biobased plastic can be used in both durable and fast-moving applications. Based on the polymer type and application, biobased plastic products can be either recycled or composted.


Did you know?
North America is the second largest producer of bioplastics in the world, with an annual production capacity of approximately 0.89 billion pounds of bioplastic resin.
Glossary
An additive is a substance blended into a polymer to modify or enhance its properties. These can include stabilizers, colorants, flame retardants, plasticizers, and fillers—each serving a specific function like improving durability, flexibility, or resistance to heat and UV light.4https://www.britannica.com/science/industrial-polymer
Advanced recycling is a process that encompasses any compositional transformation technology to convert plastics into a purified form or a feedstock that can be used in the production of new polymers, monomers, intermediates, or other materials. It is also known as chemical, molecular, tertiary, or feedstock recycling. Examples include but are not limited to depolymerization, purification, solvent extraction, gasification, and pyrolysis.5 https://www.britannica.com/science/industrial-polymer
A bioplastic is a plastic that is either biobased and/or biodegradable. Biobased plastic is a type of plastic material made from renewable biological sources—such as corn starch, vegetable fats, or sugarcane—instead of traditional fossil fuels. Some bioplastics, whether biobased or fossil based, are also biodegradable, designed to decompose completely via natural processes.6https://www.britannica.com/science/industrial-polymer
Circularity refers to designing and managing plastic materials in a way that keeps them in use for as long as possible—through reuse, recycling, and responsible end-of-life solutions.7https://www.britannica.com/dictionary/circular
Compounding is the process of mixing plastic with additives to give it special qualities, like extra strength or flexibility. For example, adding color and UV protection to plastic used for outdoor furniture helps it last longer in the sun.8https://www.britannica.com/science/industrial-polymer
Compostable plastic is a type of plastic designed to break down into natural elements like water, carbon dioxide, and organic matter when placed in a composting environment. It decomposes under specific conditions—usually involving heat, moisture, and microbes—and leaves no harmful residues behind.9https://www.britannica.com/science/industrial-polymer
Extrusion is a manufacturing process where material is forced through a shaped die to produce long objects with a consistent cross-section. It’s commonly used to make plastic pipes, window frames, and wire insulation.10https://www.britannica.com/technology/extrusion-industrial-process
A filler is a substance combined with a polymer to improve its properties or reduce production costs. Fillers can enhance strength, stiffness, thermal resistance, or even reduce shrinkage. Common fillers include materials like calcium carbonate, talc, glass fibers, and clay.11 https://www.britannica.com/technology/materials-processing
High-density polyethylene (HDPE) is a lightweight, durable plastic made by polymerizing ethylene. It’s widely used for its strength, chemical resistance, and versatility in products like laundry detergent bottles, piping, plastic bags, and containers.12https://www.britannica.com/science/high-density-polyethylene
Injection molding is a method for making plastic parts by melting plastic resin and injecting the molten material into a mold under high pressure. Once it cools and solidifies, the mold opens and the part is ejected.13https://www.sciencedirect.com/topics/materials-science/injection-molding
Low-density polyethylene (LDPE) is a flexible, lightweight plastic with lower strength and stiffness than HDPE. It’s commonly used in plastic bags, film wrap, squeeze bottles, and wire insulation due to its ductility and moisture resistance.14 https://www.sciencedirect.com/topics/engineering/low-density-poly-ethylene#:~:text=Low%20density%20polyethylene
Mechanical recycling is the process of recovering plastic waste through physical processes like sorting, washing, drying, grinding, re-granulating, and compounding without changing chemical structure. In basic terms, this common method cleans the plastic then breaks it down into smaller pieces where it then can be melted into new plastic pellets used to make new products, allowing materials to be recycled multiple times.15https://recyclingisreal.com/
Microplastics are tiny plastic particles—the most commonly cited range for microplastics is 5 millimeters (mm) down to 1 nanometer (nm).16 https://lp.plasticsindustry.org/hubfs/2025%20Positives%20of%20Plastic/PLASTICS%20Microplastics%20Policy%20Position%20August%202025%20Educational%20Focus.pdf
A monomer is a small molecule that serves as a basic building block for larger structures called polymers. These molecules can chemically bond with other monomers—often in long chains or complex networks—to form materials with diverse properties.17https://www.britannica.com/science/monomer
Nanoplastics are extremely small plastic particles—typically less than 1 micrometer in size—that result from the breakdown of larger plastic items or are manufactured for specific uses.18https://www.britannica.com/technology/nanoplastics
Plastic is a versatile material made primarily from one or more organic polymers with large molecular structures. It is solid in its final form and can be shaped or molded during manufacturing through processes that involve heat and flow. This ability to be formed into a wide range of shapes makes plastic essential in countless applications across industries.19https://www.britannica.com/science/plastic
A member of the polyester family of polymers, polyethylene terephthalate (PET) is a strong, stiff synthetic material that can be made into fibers for fabric or materials like disposable beverage bottles.20 https://www.britannica.com/science/polyethylene-terephthalate
A polymer is a substance made up of very large molecules formed by linking together many smaller, repeating units called monomers. These molecules can be arranged in long chains, branched structures, or complex networks.21https://www.britannica.com/science/polymer
Polymerization is the process in which monomers, or small molecules, combine chemically to produce a very large chainlike or network molecule, called a polymer.22https://www.britannica.com/science/polymerization
Polypropylene is a tough, lightweight plastic made by polymerizing propylene. It’s widely used in packaging, automotive parts, textiles, and reusable containers due to its strength, flexibility, and resistance to heat and chemicals.23https://www.britannica.com/science/polypropylene
Polystyrene is a synthetic resin produced by the polymerization of styrene. It’s commonly used in disposable cutlery, CD cases, insulation, and packaging due to its rigidity and clarity.24https://www.britannica.com/science/polystyrene
Polyvinyl chloride (PVC) is a durable synthetic plastic made by polymerizing vinyl chloride. It’s commonly used in pipes, window frames, flooring, and medical equipment due to its strength, versatility, and resistance to moisture and chemicals.25https://www.britannica.com/science/polyvinyl-chloride
A resin is the raw material—usually a synthetic organic compound—that serves as the starting point for making plastic products. These resins are typically supplied in the form of pellets or liquid and are made up of polymers that can be shaped and hardened through various manufacturing processes.26https://www.britannica.com/science/resin
Single-use plastics are items that are designed to be used once and then discarded or recycled. These plastics are commonly found in packaging and service items like bags, bottles, wrappers, and straws.27https://www.britannica.com/procon/single-use-plastics-debate
Thermoplastics are plastics that soften when heated and harden when cooled—repeatedly—without changing their chemical structure. They’re versatile and recyclable, commonly used in water bottles, food containers, and packaging films.28https://www.britannica.com/science/thermoplastic
Thermoset plastics are materials that permanently harden after being cured by heat or chemicals and cannot be remelted or reshaped. They’re valued for their durability and heat resistance, and are commonly used in electrical insulators, cookware handles, and adhesives.29https://www.britannica.com/technology/materials-science/Thermosets

